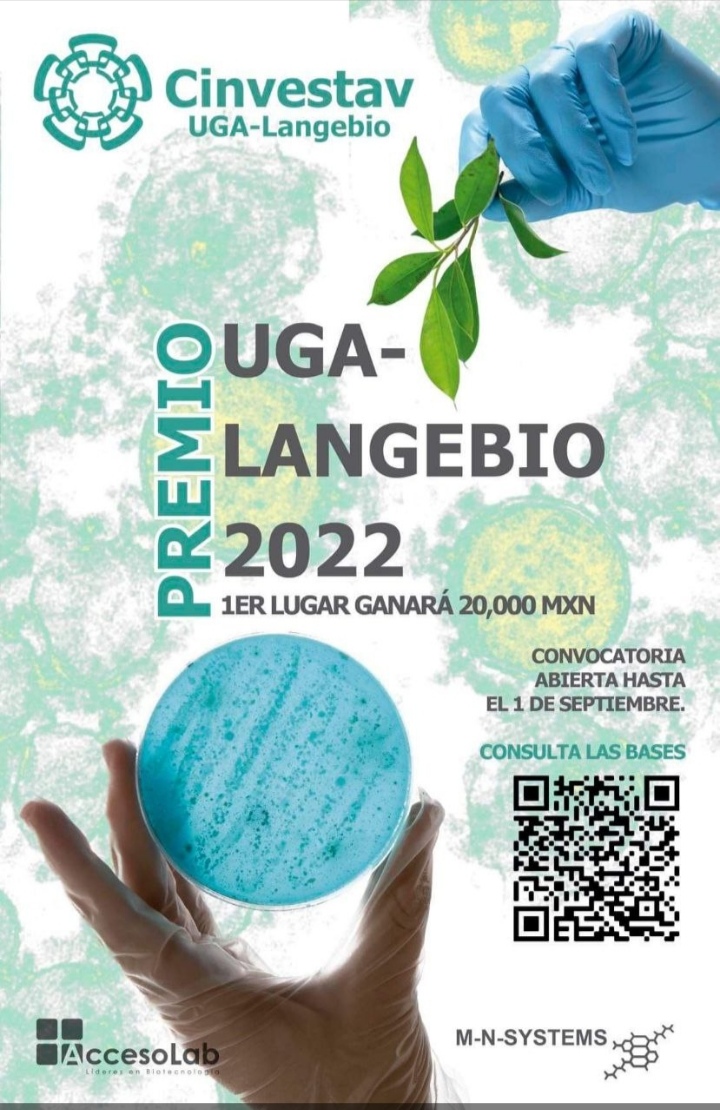

El investigador emérito de la Unidad de Genómica Avanzada Langebio, Alfredo Herrera Estrella, dijo que espera cambios positivos para la ciencia con Claudia Sheinbaum, presidenta de México.
Unidad de Genómica Avanzada
Cinvestav anuncia día abierto; convocan a familias irapuatenses
El ‘Día Abierto’ se llevará a cabo el sábado 5 de octubre, en un horario de 10:00 de la mañana a 6 de la tarde.
Elige EMBO a Luis Herrera Estrella, como miembro de la Organización
En el aniversario 60 de la EMBO, fueron elegidos 120 científicos de toda Europa y fuera de ella para ser Miembros de la Organización, este reconocimiento es un honor que celebra la excelencia investigadora y los logros sobresalientes.
Dr. Alfredo Herrera entre los 10 mejores científicos
El Dr. Alfredo Heriberto Herrera Estrella está incluido en el prestigioso ranking de los mejores científicos en las áreas de biología y bioquímica.
Regresa premio UGA Langebio
Con la finalidad de reconocer a un proyecto de investigación, este 2022 regresa el premio UGA Langebio.